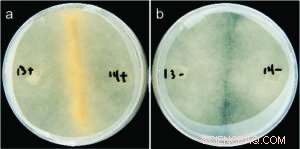
Bacteria Are Key Regulators of Fungal Reproductive Machinery

Sexual reproduction in Rhizopus microspores: (a) Successful mating between fungi harboring bacteria; (b) Lack of sex between mates cured of endobacteria. Credit: Stephen Mondo
To better understand how beneficial organisms (symbionts) are transmitted between host generations, researchers investigated the role of bacterial that lives within its host (endosymbionts) has on fungal host reproduction, and the reproductive genes they regulate. The bacterial endosymbiont, Burkholderia, is recognized as a mutualist, where both species of organism benefit from association, but was predicted to have evolved from a parasitic interaction with their soil fungus host, Rhizopus microsporus . Researchers found that endobacteria establishing control over reproduction was a likely key to this evolutionary transition. Using this model, researchers also generated the first transcriptomic dataset of sexual reproduction in early fungi and discovered genes that are critical for this process.
In the absence of the Burkholderia endobacteria, the Rhizopus fungus cannot act as a plant pathogen, it cannot reproduce asexually, and researchers have now discovered that endobacteria also regulate its sexual reproduction. The work sheds light on a poorly understood group of oleaginous or oil-producing fungi, and the impact this mutualistic interaction has on these potential large-scale biodiesel producing fungi.
In heritable mutualisms, hosts pass on beneficial symbionts between generations. The origin of this relationship though, is often antagonistic and the parasite first needs to secure its own transmission before working with the host. Using the mutualistic relationship between the plant pathogenic fungus Rhizopus microsporus (Rm) and Burkholderia endobacteria, a collaborative effort led by researchers at Cornell University and scientists at the Joint Genome Institute, a DOE Office of Science User Facility was conducted to understand how the antagonistic-to-mutualistic transition occurs. Rhizopus is a fungal pathogen of crops, including candidate bioenergy feedstocks sunflower, and maize, and a part of the oil-producing Mucoromycotina group, about which little is known. The Cornell team cultivated and experimented with the fungi and bacteria, while the DOE JGI team sequenced and annotated a host genome (Rm ATCC 52813) as part of the 1000 Fungal Genomes project.
As reported in the November 29, 2017 issue of Nature Communications, the team found that the fungus is highly dependent on the Burkholderia endobacteria to proliferate both sexually and asexually. This dependence is consistent with the addiction model of mutualism evolution; in this case, the endobacteria control the expression of ras2-1, a gene crucial to reproductive development, making the fungus reliant on the continued presence of the bacteria. By studying the Rm-Burkholderia symbiosis model, the team was able to reconstruct the reproductive pathways in several branches of the fungal kingdom, generating the first transcriptomic dataset of sexual reproduction in early fungi to find sex relevant genes across fungi. They also uncovered candidate genes, conserved across all Mucoromycotina, that appear to be involved in identifying pheromones that are critical for this fungal reproductive pathway.
Without the mutualistic Rm-Burkholderia relationship, Rhizopus is neither a plant pathogen nor able to reproduce with ease. So far, all endosymbionts discovered in fungi have been shown to substantially impact host lipid metabolism. As these oil-producing fungi are potential sustainable sources of alternative fuels, so understanding fungal-bacterial relationships can shed light on how these interactions influence lipid production in Mucoromycotina and their potential for industrial use.